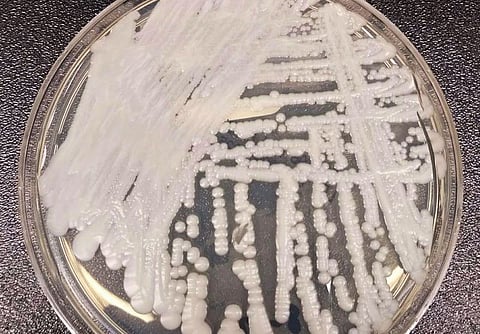

Photo: CDC
TUESDAY, Sept. 7, 2021 (HealthDay News) -- The multidrug-resistant yeast, Candida auris, can be identified and contained with enhanced laboratory surveillance and prompt investigation with infection prevention and control (IPC) support, according to a study published online Sept. 7 in the Annals of Internal Medicine.
Ellora N. Karmarkar, M.D., from the U.S. Centers for Disease Control and Prevention in Atlanta, and colleagues examined the prevalence of C. auris and IPC practices in three long-term acute care hospitals (LTACHs) and 14 ventilator-capable skilled-nursing facilities (vSNFs) serving adult patients in Orange County, California, in 2019.
The first case of C. auris was identified in February 2019 in a patient in an LTACH. The researchers found that initial point prevalence surveys (PPSs) at 17 facilities identified 44 patients with C. auris in three LTACHs and six vSNFs (100 and 43 percent, respectively); the first bloodstream infection was reported in May 2019. A total of 182 patients with C. auris were identified by October 2019 by serial PPSs and discharge testing. All 81 isolates that were sequenced were clade III and highly related. Gaps in hand hygiene, transmission-based precautions, and environmental cleaning were identified on assessment of IPC. By October 2019, the outbreak was contained to two facilities.
"Implementing enhanced laboratory surveillance and rapid, countywide investigation to assess the burden of C. auris and strengthen IPC practices in high-risk facilities limited transmission in Orange County through 2019," the authors write. "Our approach can inform future containment efforts for C. auris and other emerging multidrug-resistant organisms, in California and nationwide."
Abstract/Full Text (subscription or payment may be required)